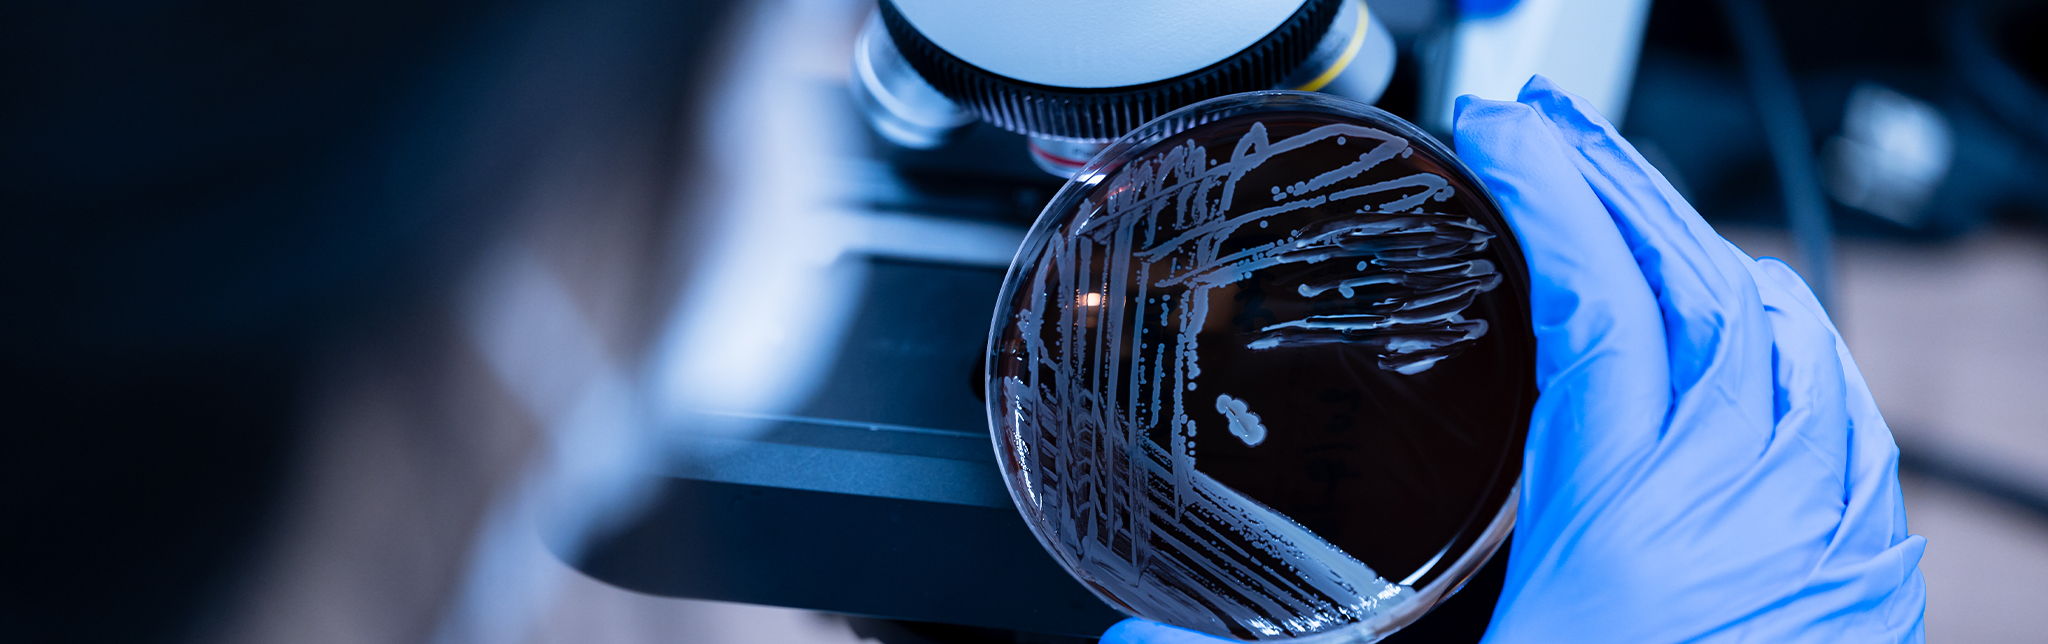

バイオバーデン測定
バイオバーデンは、材料や製品上(中)に存在する生育可能な微生物の集団です。細菌や真菌が対象で、ウィルスは対象になっていません。多数のバイオバーデン測定の方法がありますが、主な2種類の方法について紹介いたします。
培地浸漬法

測定試料を寒天培地の中に埋没させて培養し、コロニー数を計測する方法です。
写真のように、菌の存在部位が赤く発色することにより確認できます。微生物を取り出す必要がないので、回収率測定が不要で、精度の高い測定が可能です。
洗い出し法

測定試料を回収液の中に入れ、物理的な方法で菌を試料から回収液に移行させます。
その回収液をメンブランフィルターで濾過後培養し、コロニー数を計測する方法です。この方法は回収率により菌数を補正する必要があります。



